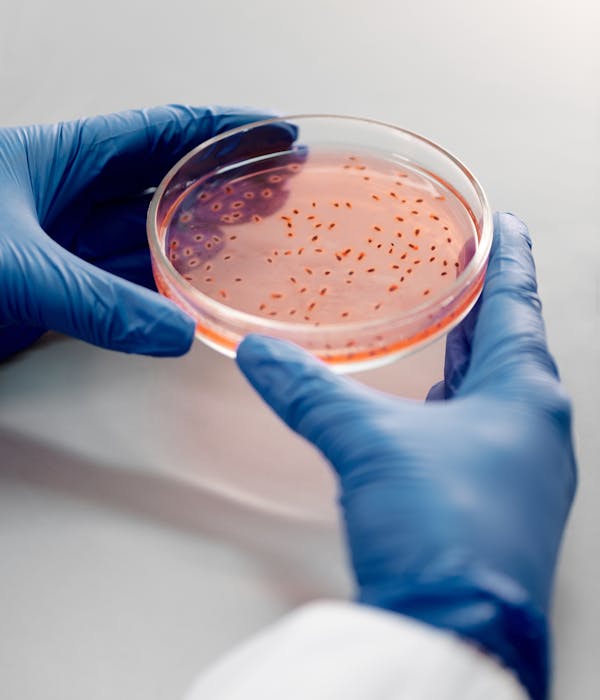
Image Description

Tauchen Sie ein in die Zukunft
Entdecken Sie Nano Immuno Tech: Ihr Partner für globale Lösungen in der Nanobiotechnologie und DNA Technologie. Jetzt revolutionär!







Vertrauenswürdig bei den Besten

Innovation
Revolutionäre Nanobiotechnologie für globalen Fortschritt
Nano Immuno Tech bietet zukunftsweisende Lösungen in der Nanobiotechnologie und DNA Technologie
-
1. Effizientere Forschung
-
2. Höhere Genauigkeit
-
3. Fortschrittliche Diagnosen
Nano-Innovation für Biotech-Unternehmen
Nano-Innovation: Entdecken Sie neue globale Lösungen heute
Innovative Nanobiotechnologie für Biotech-Unternehmen. Entdecken Sie neue globale Lösungen heute. Steigern Sie Ihre Forschung und Entwicklung
25%
Steigerung der Bindung
1.7X
Benutzerbasiswachstum

Integrierung ohne den Stress




KUNDENMEINUNG
Was Unsere Kunden Sagen
Nano Immuno Tech hat meine Erwartungen übertroffen! Die innovative Nanobiotechnologie hat mir geholfen, meine Gesundheit zu verbessern

John Davis
CEO
Testimonial 2: "Seit ich Nano Immuno Tech verwende, fühle ich mich vitaler und widerstandsfähiger. Ein echter Durchbruch in der DNA Technologie!"
"Nano Immuno Tech hat meine Erwartungen übertroffen! Die innovative Nanobiotechnologie hat mir geholfen, meine Gesundheit zu verbessern."
"Ich bin begeistert von den globalen Lösungen, die Nano Immuno Tech in der Nanobiotechnologie bietet. Absolut empfehlenswert!

Michael Rodriguez
Developer
Absolut empfehlenswert!

Lisa Evans
Freelancer
Häufig gestellte Fragen (FAQ)
Häufig gestellte Fragen
Wir haben einige häufig gestellte Fragen zusammengestellt
Frage 1: Welche Art von globalen Lösungen bietet Ihr Unternehmen in der Nanobiotechnologie an?
Unser Unternehmen bietet innovative und umfassende globale Lösungen in der Nanobiotechnologie sowie der DNA-Technologie an
Frage 2: Welche Vorteile bieten Ihre Lösungen im Bereich Nanobiotechnologie?
Unsere Lösungen im Bereich Nanobiotechnologie bieten die Möglichkeit zur Entwicklung hochmoderner Technologien und Anwendungen auf globaler Ebene
Frage 3: Ist Ihr Unternehmen auf spezifische Branchen spezialisiert?
Wir bieten unsere Lösungen in der Nanobiotechnologie und DNA-Technologie branchenübergreifend an und passen sie individuell an die Bedürfnisse unserer Kunden an
Frage 4: Unterstützen Sie auch bei der Implementierung und Schulung im Umgang mit den Lösungen?
Ja, wir bieten umfassende Unterstützung bei der Implementierung unserer Lösungen an und schulen die Anwender, um einen reibungslosen Einsatz zu gewährleisten
Frage 5: Welche Erfahrung und Fachwissen bringen Ihre Experten in den Bereichen Nanobiotechnologie und DNA-Technologie mit?
Unsere Experten verfügen über langjährige Erfahrung und umfangreiches Fachwissen in den Bereichen Nanobiotechnologie und DNA-Technologie, um unseren Kunden erstklassige Lösungen bieten zu können
Frage 6: Bieten Sie auch maßgeschneiderte Lösungen für spezifische Projekte an?
Ja, wir arbeiten eng mit unseren Kunden zusammen, um maßgeschneiderte Lösungen für deren spezifische Projekte im Bereich Nanobiotechnologie und DNA-Technologie zu entwickeln
Sehen Sie alles, woran das Team arbeitet